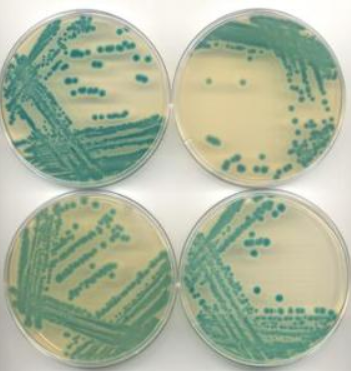
马丁培养基

马丁培养基

马丁液体培养基
图片尺寸650x650
马丁培养基
图片尺寸351x371
改良马丁培养基 生物试剂250g/瓶 正品 北京奥博星
图片尺寸563x898
改良马丁琼脂培养基 250g hb4701霉菌无菌试验 海博生物包邮含票
图片尺寸800x800
hopebio海博生物改良马丁琼脂培养基
图片尺寸800x800
改良马丁琼脂培养基 250g/瓶 杭州微生物 m0143
图片尺寸800x800
改良马丁培养基干粉用于药品生物制品中真菌的无菌检验
图片尺寸800x800
瑞楚生物 改良马丁琼脂培养基 预装培养皿 tp695 90mm 10皿 包
图片尺寸800x800
马丁肉汤培养基 生化试剂 br 马丁肉汤培养基 250g 货号02-088
图片尺寸750x1000
改良马丁液体培养基
图片尺寸400x400
改良马丁培养基 250g北京奥博星02-037霉菌无菌检验
图片尺寸1180x1180
供应马丁培养基
图片尺寸650x650
改良马丁琼脂培养基货号hb4701
图片尺寸500x500
化科 baisi 改良马丁琼脂培养基 martin agar medium ,medium 250g
图片尺寸800x800
改良马丁琼脂培养基颗粒
图片尺寸400x400
soc培养基 250g克 基因工程菌大肠杆菌培养 杭州百思 中山百微
图片尺寸800x800
马丁肉汤培养基 生化实验试剂 250g
图片尺寸800x800
改良马丁培养基海博生物上海生物网hb5222
图片尺寸800x800
021040 改良马丁液体培养基药品生物制品无菌检查真菌培养基
图片尺寸800x800
惠利得改良马丁液体培养基
图片尺寸800x800